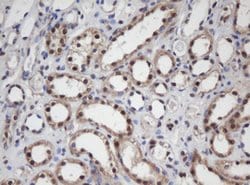
APEX1 Mouse anti-Canine, Human, Clone: OTI1H9, lyophilized, TrueMAB 100

Learn More
APEX1 Mouse anti-Canine, Human, Clone: OTI1H9, lyophilized, TrueMAB™
Mouse Monoclonal Antibody
Brand: Origene Technologies CF800330

Description
Reconstitute with PBS (pH 7.3) and recommend to perform another round of desalting process using Product No. 7KMWCO
Apurinic/apyrimidinic (AP) sites occur frequently in DNA molecules by spontaneous hydrolysis, by DNA damaging agents or by DNA glycosylases that remove specific abnormal bases. AP sites are pre-mutagenic lesions that can prevent normal DNA replication so the cell contains systems to identify and repair such sites. Class II AP endonucleases cleave the phosphodiester backbone 5′ to the AP site. This gene encodes the major AP endonuclease in human cells. Splice variants have been found for this gene; all encode the same protein.Specifications
| APEX1 | |
| Monoclonal | |
| Unconjugated | |
| APEX1 | |
| APE, APE1, APEN, APEX, APX, HAP1, REF1 | |
| Mouse | |
| Affinity Chromatography | |
| RUO | |
| 328, 482558 | |
| -20° C, Avoid Freeze/Thaw Cycles | |
| Lyophilized |
| Immunohistochemistry (Paraffin), Western Blot | |
| OTI1H9 | |
| PBS with 8% trehalose and no preservative; pH 7.3 | |
| P27695 | |
| APEX1 | |
| Human recombit protein fragment corresponding to amino acids 1-242 of human APEX1 produced in E.coli. | |
| 100 μg | |
| Primary | |
| Canine, Human | |
| Antibody | |
| IgG1 |
The Fisher Scientific Encompass Program offers items which are not part of our distribution portfolio. These products typically do not have pictures or detailed descriptions. However, we are committed to improving your shopping experience. Please use the form below to provide feedback related to the content on this product.